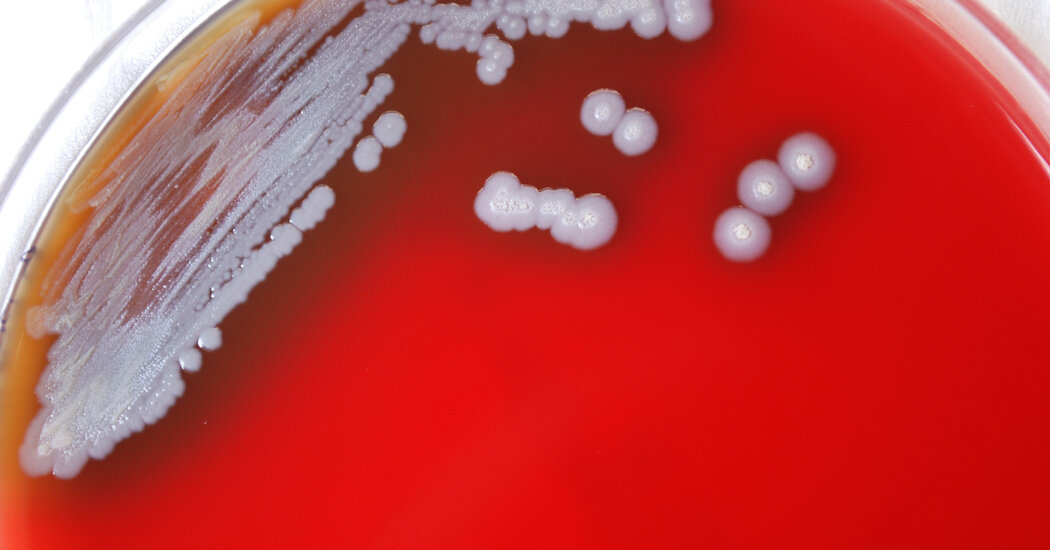

Nancy Rhine, a gerontologist and marriage and family therapist in Mill Valley, Calif., has helped about 40 older adults prepare for and process late-life rituals involving hours of retrospection and introspection, art and music. “They’re looking at legacy, life review, taking stock,” she said. “It’s that searching, a contemplative practice.” Her oldest such client was […]

Diagnostic confusion also seemed to have played a role in the Sandals case. The night before they were supposed to check out, two of the people who died, Robbie Phillips, 65, a travel adviser who was actually one of the top sellers for Sandals, and her husband, Michael, 68, visited a medical facility complaining of […]

Monkeypox, once a relatively obscure virus endemic to Africa, has bloomed into a global threat, infecting more than 20,000 people in 75 countries and forcing the World Health Organization to declare a worldwide health emergency. On Thursday, New York State and San Francisco declared emergencies of their own. But even as the national tally nears […]
A potentially deadly bacteria was found for the first time in water and soil samples in the United States, prompting the Centers for Disease Control and Prevention to alert doctors and public health experts throughout the country on Wednesday to take it into consideration when examining patients. The bacteria, Burkholderia pseudomallei, was detected in the […]

So she started to provide a replacement for the street drugs, first Dilaudid, then fentanyl patches, and, now, the fentanyl capsules. Her project purchases the fentanyl from a pharmaceutical manufacturer, and a local pharmacy compounds it, with dextrose and caffeine as buffers. The pills are sold at $10 a hit, priced to match the street […]

Teva Pharmaceuticals, one of the country’s biggest manufacturers of generic opioids, announced a settlement in principle with some 2,500 local governments, states and tribes over the company’s role in the deadly, ongoing opioid epidemic. The deal — worth up to $4.25 billion — came after a series of blistering trials and previous settlements in individual […]

Barely a month after the Food and Drug Administration authorized Covid-19 vaccines for very young children, the prognosis that large numbers of them will actually get the shots looks bleak, according to a new survey of parents released on Tuesday by the Kaiser Family Foundation, which has monitored vaccine attitudes throughout the pandemic. A majority […]

For Ellie Alvarado, a teacher and mother of three in Elgin, Ill., figuring out how to pay the bills has become a source of anxiety and tension, especially when she and her husband argue over how to cut back. “When I say, ‘OK we cannot buy anything this week or else we’ll go into overdraft’ […]

For the second time in two years, the World Health Organization has taken the extraordinary step of declaring a global emergency. This time the cause is monkeypox, which has spread in just a few weeks to dozens of countries and infected tens of thousands of people. Dr. Tedros Adhanom Ghebreyesus, the W.H.O.’s director general, on […]

In April of last year, Rachel Brown’s oncologist called with bad news — at age 36, she had an aggressive form of breast cancer. The very next day, she found out she was pregnant after nearly a year of trying with her fiancé to have a baby. She had always said she would never have […]